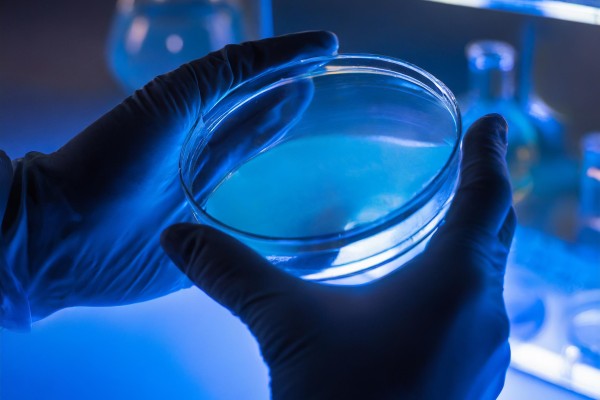
What Does Antimicrobial Mean?

Blog
Featured Articles
-

Does Silver Kill Bacteria?
For centuries, silver has been known for its ability to preserve freshness and combat infection. But how does it actually work? Does silver really kil...
-

E. coli Bacteria: What It Is, How You Catch It, and How to Avoid It
E. coli (Escherichia coli) is a group of bacteria commonly found in the intestines of humans and animals. While many strains are harmless, certain typ...
-

Why Cleanroom Flooring Matters in EV Battery Plants
As the world shifts towards more sustainable transportation, electric vehicle (EV) battery plants are becoming central to industrial development. Thes...
-

Understanding Microplastics and Human Health
What are microplastics? When I first started exploring microplastics, I was surprised by how misunderstood they are. At their simplest, microplastics...
-

Improving Hygiene in Gyms and Fitness Equipment
Gyms are hotspots for health and wellness — but also for bacteria. With hundreds of people sharing equipment, lockers, mats, and showers each da...
-

How Many Bacteria Are Lurking on Everyday Surfaces?
We often associate bacteria with obvious culprits like toilet seats and rubbish bins. But in reality, some of the most contaminated surfaces are the o...
-

Mysophobia: What It Is, Causes, Symptoms, and How to Cope
Mysophobia, also known as germophobia, is the excessive fear of germs, dirt, and contamination. While it's natural to want to stay clean and avoid ill...
-

Top 10 Microbial Hotspots
Microbes are everywhere. While many are harmless, certain types can spread illness and thrive on high-touch surfaces. These "microbial hotspots" are p...
-

How Antimicrobial Shower Heads Improve Bathroom Hygiene
Bathrooms are meant to be hygienic — but your shower head might be hiding a dirty secret. Warm, damp environments are ideal breeding grounds for...
-

What Are Antimicrobial Coatings and Why Are They Essential?
Antimicrobial coatings are surface treatments enhanced with additives that inhibit the growth of bacteria, mould, fungi, and even algae. Unlike disinf...
-

The Growing Importance of Hygiene in Electronics
In our ever more interconnected world, electronic devices such as smartphones, tablets, VR headsets, laptops, and keyboards have become indispensable...
-

Top 10 Industries That Benefit Most from Antimicrobial Additives
In today’s hygiene-conscious world, antimicrobial additives are no longer a luxury – they are a critical part of product design and develo...
-

Why Antimicrobial Technology is Essential
Microbes are ever-present in daily environments, affecting a wide range of everyday items, including kitchen surfaces, clothing, packaging, and medica...
-

Targeted Hygiene: Insights from IFH’s Latest Study
In response to the increasing global focus on infection control and hygiene resilience, the International Scientific Forum on Home Hygiene (IFH) recen...
-

What is E. coli? Causes, Symptoms, and Prevention
E. coli, short for Escherichia coli, is a type of bacteria that naturally lives in the intestines of humans and animals. While most strains are harmle...
-

The Future of Automotive Seating with ONVO & Biomaster
Addmaster’s collaboration with ONVO marks a step forward in automotive material innovation. By integrating Biomaster antimicrobial technology in...
-

How Long Can Bacteria Live on a Surface?
Bacteria are microscopic organisms that can survive on various surfaces for different periods, depending on environmental conditions and the type of b...
-

Biomaster Antimicrobial Technology in Healthcare Environments
In healthcare, maintaining the highest standards of hygiene is not just a requirement - it’s a responsibility. Every surface, tool, and device p...
-

How Long Can E. Coli Survive on Surfaces?
When it comes to maintaining a germ-free home, understanding the survival tactics of harmful bacteria like E. coli is crucial. This resilient pathogen...
-

Redefining Oral Care with Okamura Toothpicks
For over a century, the Okamura Group has been a trusted name in oral care, consistently delivering high-quality products that prioritise customer wel...
-

Enhancing Water Hygiene with Biomaster Technology
Maintaining water hygiene is a high priority in healthcare and other sensitive environments. FrankLab, a leader in water filtration technology, and a...
-

A Revolutionary Approach to Poultry Farming with Dripple Care
Water quality is the foundation of success when it comes to poultry farming, impacting not only the health and welfare of livestock but also their ove...
-

What is Germophobia?
Understanding Germophobia Germophobia, also known as mysophobia, is an intense fear of germs, bacteria, and contamination. While many people take rea...
-

Plastics in Modern Architecture and Construction
Plastics have become indispensable in contemporary architecture and construction due to their exceptional versatility, durability, and cost-effectiven...
-

Cruise Control: Antimicrobial Technology and Ship Hygiene
Cruise ships are a marvel of modern travel, offering passengers the opportunity to explore exotic locations while enjoying world-class amenities. Howe...
-

10 Facts About Silver as an Antimicrobial
Silver has long been celebrated for its antimicrobial properties, with a history that spans thousands of years. From ancient civilisations using it to...
-

Why Antimicrobial Technology is an Important Investment for Every Industry
As industries globally place increasing emphasis on hygiene, antimicrobial additive technology has become a critical tool in creating more hygienic en...
-

The Role of Silver in Antimicrobial Additive Technology
Silver has been revered for centuries as a powerful and reliable antimicrobial agent, with ancient civilisations recognising its ability to preserve f...
-

How Long Can MRSA Survive on a Surface?
Methicillin-resistant Staphylococcus aureus (MRSA) is a dangerous bacterium known for its resistance to many antibiotics. It is a major cause of healt...
-

The Future of Care Home Dining with Antimicrobial Tableware
In recent years, more so since the pandemic, hygiene has become of paramount concern, especially in healthcare environments including care homes where...
-

Microbial Survival on Surfaces: Challenges and Solutions
Microorganisms, including bacteria, viruses, and fungi, have the ability to persist on surfaces for extended periods, creating significant hygiene cha...
-

Verimaster Anti-Counterfeit Technology: Protection for Your Brand
In today’s global market, counterfeiting has emerged as a pervasive issue, with estimates indicating that approximately 7% of all world trade in...
-

Enhancing Clinical Workflow with Advanced Nurse Call Solutions
The Evolution of Nurse Call Systems Nurse call systems have undergone a significant transformation over the years. Traditionally, these systems funct...
-

Plastics and Polymers - What's the Difference?
Understanding the difference between plastics and polymers requires a foundational knowledge of what polymers are and how they relate to plastics. Po...
-

Listeria Explained: History and Characteristics of the Bacterium
Listeria monocytogenes is a bacterium of significant concern in the field of food safety and public health. While not as widely recognised as pathogen...
-

Antimicrobial Technology for Enhanced Hygiene in Care Homes
There are numerous news stories on an almost weekly basis talking about care homes struggling with hygiene management. This reporting highlights a cri...
-

Campylobacter Explained: History and Characteristics of the Bacterium
Campylobacter is a genus of bacteria that stands out as one of the leading causes of foodborne illnesses globally, affecting millions of people each y...
-

Famous Germaphobes: 5 More Celebrities With Mysophobia
Germophobia—also known as mysophobia, verminophobia, and bacillophobia—is a pathological fear of germs, bacteria, uncleanliness, contamina...
-

Silver-Ion Antimicrobial Technology in Smart Devices
Digital devices have revolutionised our daily lives, significantly enhancing our communication, productivity, and entertainment. However, they can als...
-

Biomaster: A Game-Changer in Antimicrobial Packaging
When it comes to packaging, the integration of antimicrobial technology has become extremely important. At the forefront is Biomaster antimicrobial te...
-

Antimicrobial Additives in 3D Printing Filaments
The advent of 3D printing has ushered in a paradigm shift in the way we conceptualise and produce objects. This groundbreaking technology has revoluti...
-

E. coli Explained: History and Characteristics of the Bacterium
Escherichia coli (E. coli) is a Gram-negative, rod-shaped bacterium that is commonly found in the intestines of humans and warm-blooded animals. It is...
-

The Role of Scent Marketing with Scentmaster
In today's fiercely competitive market, businesses are in a constant quest for innovative strategies to distinguish themselves and forge enduring conn...
-

Antimicrobial Additives Within Cleanroom Environments
Cleanrooms serve as essential facilities in industries where the utmost cleanliness and sterility are imperative to ensure product quality and complia...
-

Deep Vein Thrombosis in the Gaming Community
In the ever-growing gaming industry, where virtual worlds captivate billions, gaming related threats continue to build. However, a silent threat lurks...
-

Antimicrobial Technology: The Future of VR Hygiene
Virtual Reality (VR) technology has rapidly evolved from a niche hobby to a widespread tool with applications in personal entertainment, education, tr...
-

Antimicrobial Additives in Gaming Accessories
In the dynamic, evolving, and ever-growing world of gaming, where players spend countless hours engaged in virtual adventures, the significance of hyg...
-

The Collaboration Between Gen Phoenix and Addmaster
Gen Phoenix are a renowned manufacturer specialising in crafting premium recycled leather for automotive, public transport, aviation, and footwear app...
-

Campylobacter in Food Processing Environments
Campylobacteriosis is a gastrointestinal infection caused by the Campylobacter bacteria and represents a considerable public health challenge globally...
-

Unlocking the Power of Antimicrobial Technologies
Antimicrobial technologies are revolutionising our lives. From everyday products such as smartphones and clothing to high-touch areas in hospitals and...
-

The Role of Antimicrobial Additives in Animal Feeders
In the agricultural industry, maintaining hygiene is paramount for the health and well-being of livestock. However, one often overlooked aspect is the...
-

Harnessing Biomaster Antimicrobial Technology in Plastisols
Hygiene is extremely important in today’s world and the integration of antimicrobial technologies has become a cornerstone across numerous indus...
-

Enhancing Hygiene in Healthcare with Antimicrobial Tableware
In healthcare and medical environments, where hygiene is paramount, every detail matters. From surfaces to equipment, maintaining a hygienic environme...
-

The Great British Train Scandal
'The Great British Train Scandal' was aired last night on UK TV. This eye-opening documentary exposed issues with the UK rail network, including just...
-

Antimicrobial Coatings: Protecting Products Against Microorganisms
Today, hygiene has become an area of focus around the world and the need for innovative solutions to protect products from microorganisms has never be...
-

Celebrity Germaphobes - Behind the Glamour
Germophobia is a term used to describe a pathological fear of germs, bacteria, uncleanliness, contamination, and infection. Germophobia, also known as...
-

Gen Phoenix's Sustainable Leather Revolution
Check out how Gen Phoenix, a valued client of Addmaster, is leading the charge in sustainable fashion with its innovative recycled leather. Based in t...
-

How Long Does Bacteria Live on a Surface?
How Long Does Bacteria Live on a Surface and the Implications for Hygiene in Specialised Environments Microbes, including bacteria, exhibit remarkabl...
-
What Does Antimicrobial Mean?
In a world teeming with microorganisms, the term "antimicrobial" has become increasingly prevalent. From household products to medical treatments, the...
-

Biomaster in Wall Coverings at the Burj Al Arab
Biomaster Used in Muraspec Wall Coverings at Gilt in the Burj Al Arab Hotel In the glittering heart of Dubai, the Burj Al Arab Hotel stands as a test...


